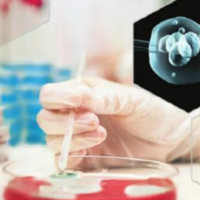

大龄试管
- 文章 (8)
- 帖子 (5)
- 问答 (2)

大龄试管选美国还是日本?核心差异帮你理性抉择
![]() 浏览量94
浏览量94

大龄试管婴儿胚胎就一个要移植吗?高龄生育与胚胎数量的现实挑战
![]() 浏览量53
浏览量53

41岁大龄试管成功经验分享,准备充足一次成功不难
![]() 浏览量53
浏览量53

44岁大龄试管成功经验大揭秘,保持心情愉快和饮食调理都是秘诀
![]() 浏览量89
浏览量89

大龄试管男士怎么调理身体好试管成功率高?
![]() 浏览量69
浏览量69
大龄试管前激素六项检查
![]() 浏览量674
浏览量674

35岁大龄试管经历,成功诞下混血龙凤胎
![]() 浏览量1665
浏览量1665

四十岁大龄试管婴儿真实经历:一个胚胎也能一次成功 要学会做这些事情
![]() 浏览量592
浏览量592

大龄试管婴儿是去日本还是泰国成功率更高呢?
问题描述:我和老婆今年都四十出头了,备孕好几年一直没动静,最后只能考虑做试管。因为年纪摆在这儿,不管是精子还是卵子质量肯定都不如年轻人,心里特别没底。我们咨询了好多家机构,发现大部分人推荐去日本,说是技术更细、服务好,但也有中介力荐泰国,觉得性价比高、筛选技术也成熟。我和老婆都快愁死了,所以问问大家到底去哪儿更好呢?最佳回答:对于大龄女性,日本试管婴儿的成功率通常更具优势。日本在胚胎培养和染色体筛...

大龄试管双胞胎:风险与应对全解析
大龄女性(通常指 35 岁以上)因卵巢功能下降,在试管婴儿治疗中,部分人会选择移植两枚胚胎以提高受孕概率,若两枚胚胎均成功着床,便形成试管双胎。但大龄与双胎妊娠的叠加,会使母体与胎儿面临的风险显著高于年轻单胎妊娠人群。了解大龄试管双胎的核心风险、影响因素及科学应对措施,能帮助大龄女性理性评估自身情况,在追求生育愿望的同时,最大程度保障母婴健康。大龄女性的生理特点与双胎妊娠的叠加风险基础要理解大龄...

大龄试管胚胎质量不好能移植吗?一文了解高龄试管胚胎选择
据统计,38岁以上女性通过试管婴儿获得的优质胚胎率不足40%,42岁以上更是骤降至15%以下。面对"质量不好"的胚胎,医生和患者往往陷入两难——移植可能面临低成功率和高流产风险,放弃则意味着要重新开始昂贵的促排周期。现代生殖医学研究表明,部分"低评分"胚胎仍具有发育潜力,关键在于科学评估和个体化决策。本文将系统分析大龄女性低质量胚胎的发育潜能、移植策略以及替...

大龄试管移植还是攒胚胎,一文教你如何做出最优选择
对于35岁以上的女性来说,试管婴儿技术已成为实现生育愿望的重要途径。然而,随着年龄增长,卵巢功能逐渐衰退,获卵数量和质量下降,使得每一步决策都至关重要。其中,立即移植可以缩短等待时间,但可能面临胚胎数量有限的风险;攒胚胎虽然耗时更长,却能提高累积成功率。这一选择不仅关系到治疗效率,更直接影响最终抱婴回家的概率。本文将系统分析两种策略的利弊,帮助大龄女性根据自身情况做出科学决策。大龄如何选择试管移植...

试管怀孕后2次胎停都是因为三体这和大龄试管有关系吗?
问题描述:我今年36岁,很早之前就检查出无法自然生育,因此就去做试管治疗。本来过程都很顺利,但我却经历了2次胎停。在最近一次检查中才知道是三体的原因导致,我想到我年龄也不小了,所以想问问胎停和大龄试管有关系吗?最佳回答:试管怀孕后2次都因为三体胎停和大龄试管有一定关系。从临床上来说,比较常见的胎停育原因就包括孕妇年龄,因此大龄孕妇在妊娠期间很大几率会出现染色体三体进而发生胎停。女性年龄较大其卵巢功...
问 45岁大龄试管自然周期取卵能成功吗?

庄乾云 副主任医师
问 广州试管成功率高的私立医院有吗,大龄试管借卵成功高吗

刘成红 主任医师
热门关注
最新TAG
更多

-

#xy染色体
对比 X 染色体 1100 + 基因与 Y 染色体独特遗传特性,详解假性常染色体区域作用,揭秘性染色体进化历程与物种特异性差异。
-

#2026备孕
2026 备孕攻略来袭!了解最新备孕趋势,掌握科学规划生育力方法,从孕前检查到营养补充,为您提供全面备孕指导,助您顺利迎接好孕。
-

#佛山试管
想在佛山做试管婴儿?这里有 2026 最新正规机构名单、单周期费用明细(含医保报销),详解三代试管 PGT 技术、胚胎筛查优势,还有不同病因(多囊 / 卵巢早衰 / 无精症)适配医院推荐,快速开启好孕路~
-

#宁波试管婴儿
宁波试管婴儿全流程指南:正规医院资质查询、国产药省钱方案、冻胚移植技巧,含 35 岁以下高成功率医院推荐,让备孕少走弯路。
-

#合肥试管婴儿
合肥 15 家正规试管机构任选,含安医附院 / 省立医院等三甲,三代试管筛查 200 种遗传病,35 岁以下妊娠率 65%+,8 项费用医保报销,免费获取医院对比与预约指南。





